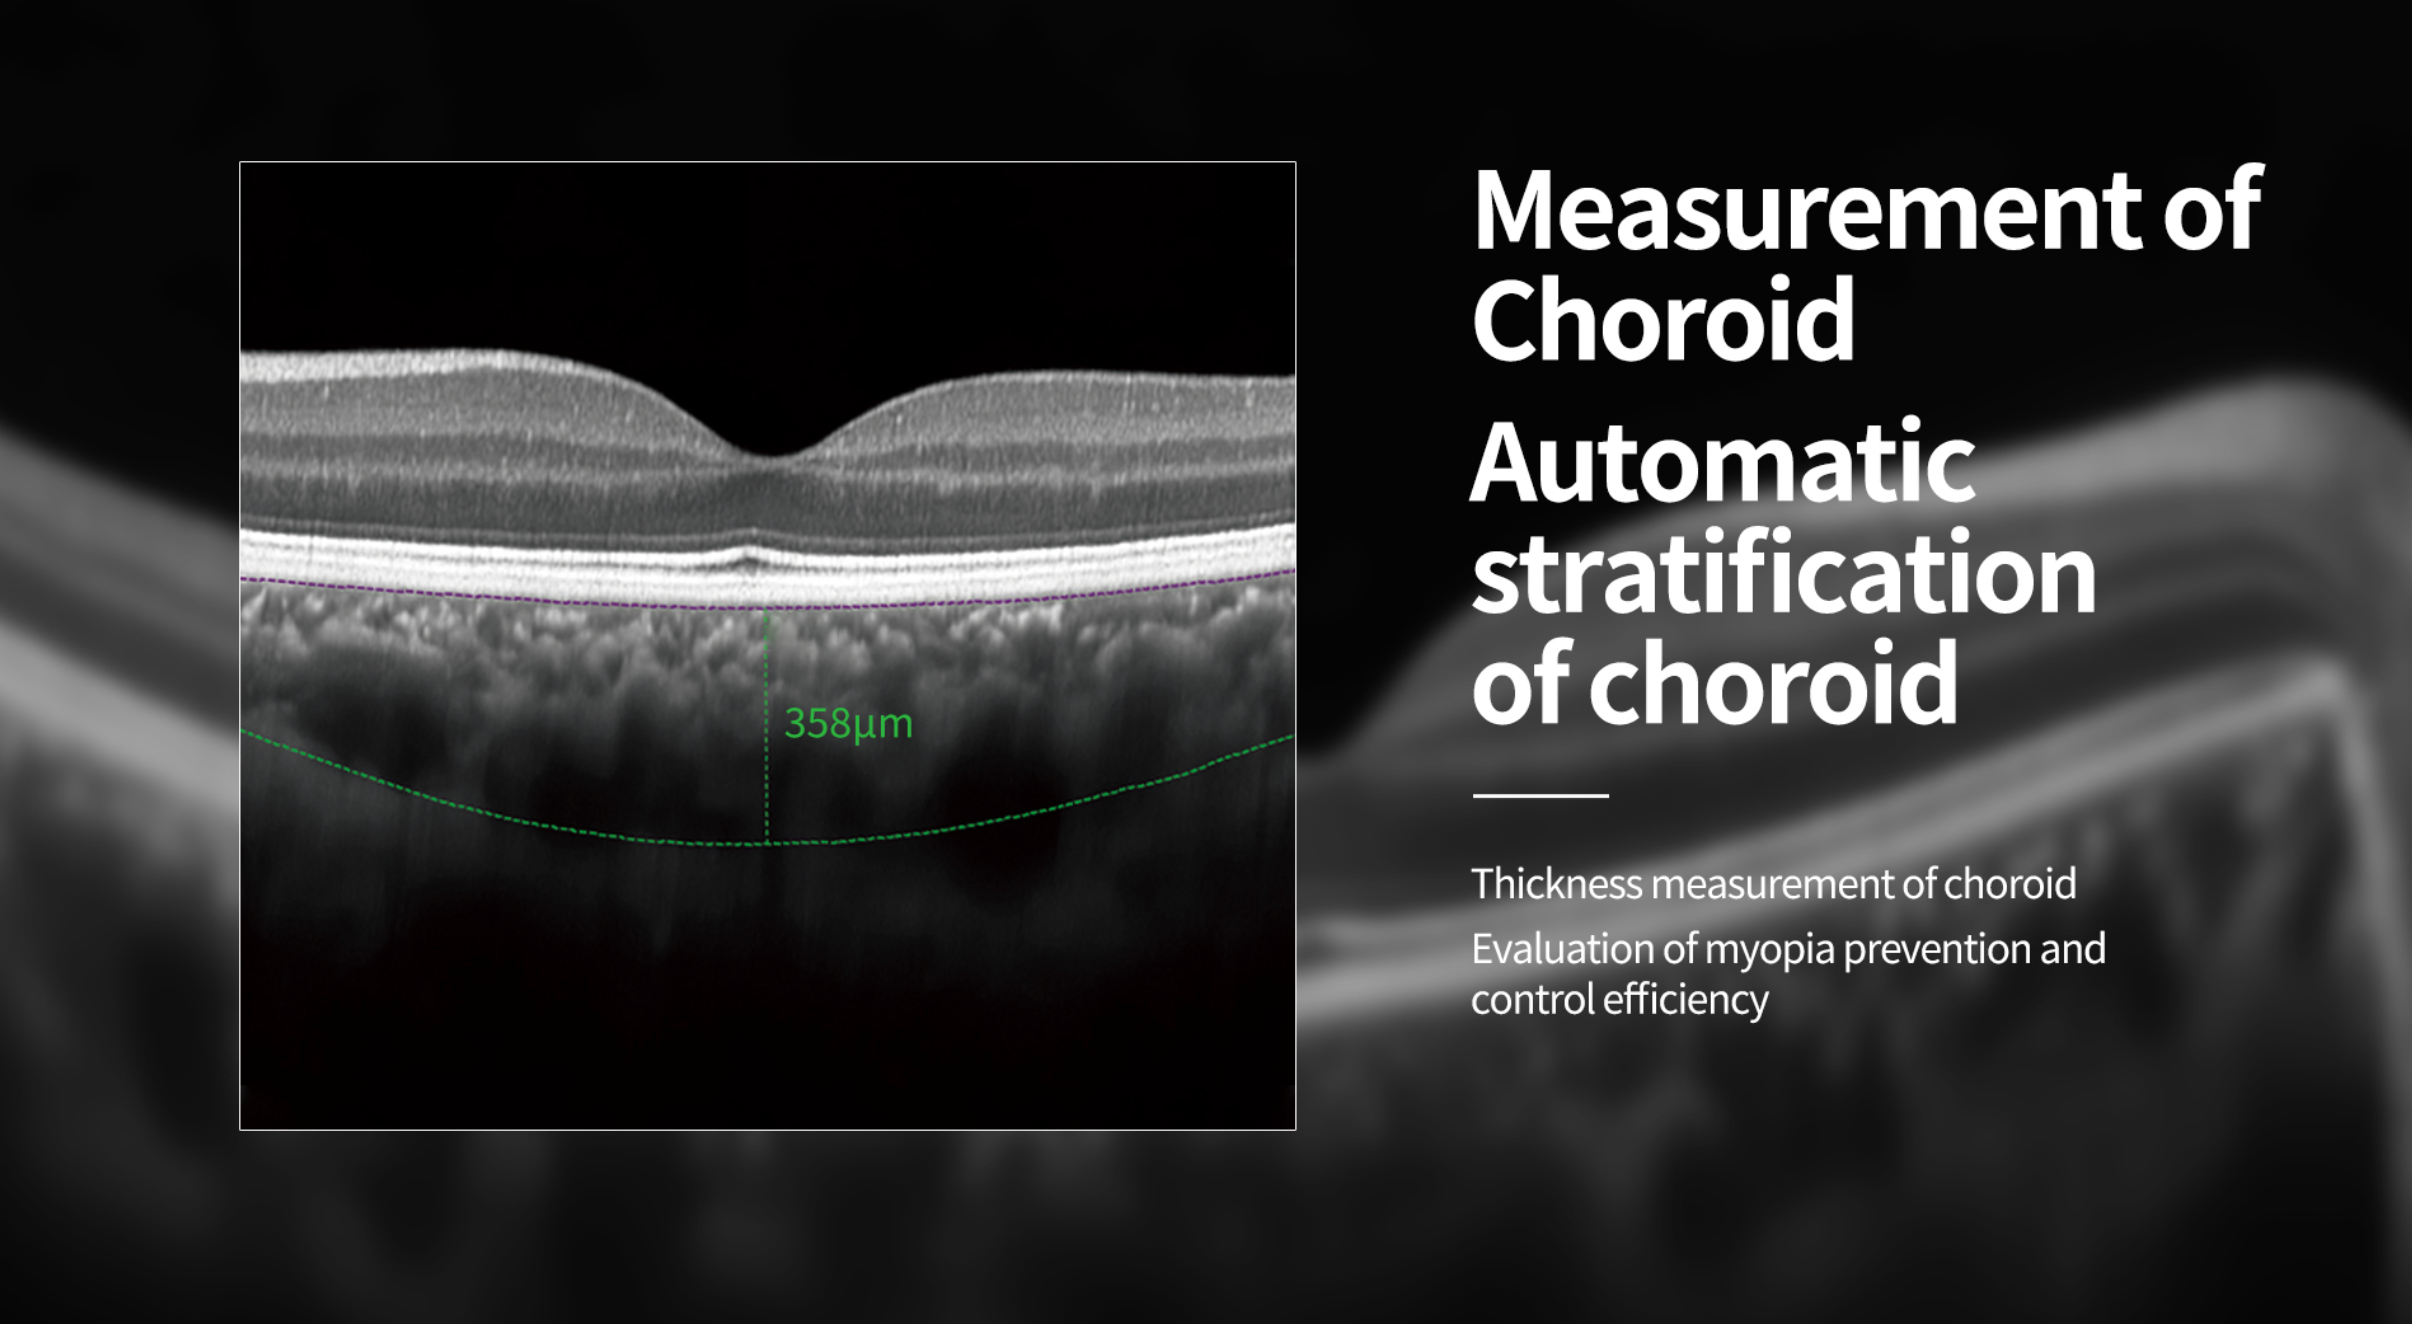
OCT Velite C-800B 86K

¿Quienes Somos?
Somos tu socio de confianza
GeneralFocus es una Start-Up multidisciplinaria creada para satisfacer una necesidad en el mercado oftalmológico de una empresa que garantice altos estándares de innovación, calidad y confianza a precios accesibles.

Especialidades





Antifaz Ocular iFlo VEM-200
Compresa caliente precisa y eficaz para el alivio de la sequedad ocular. iFlo aplica una compresa caliente localizada con una temperatura de hasta 44 °C para aflojar eficazmente las obstrucciones de las glándulas de Meibomio y mejorar la estabilidad de la película lagrimal....
Envío a todo chile
Soporte telefónico
Distribuidor autorizado
Equipos destacados
Cámara Retinal Ultra Wide Field RetiCam PLUS


Nuestros proyectos
A lo largo de los años hemos tenido la oportunidad de trabajar con empresas increíbles y crear proyectos que perduran en el tiempo
Nuestras marcas


Nuestras marcas


Nuestras marcas


Nuestras marcas